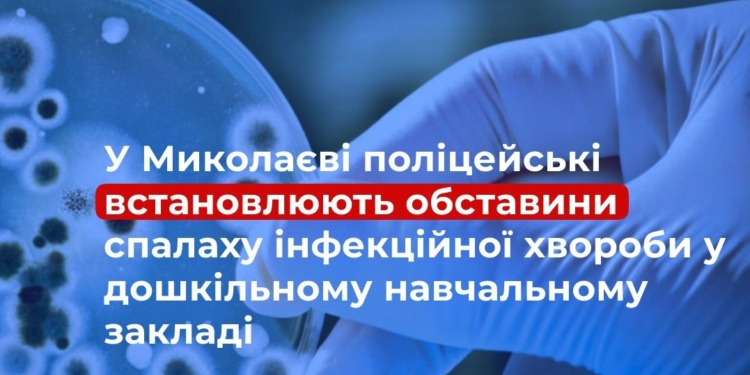
У Миколаєві спалах гострої кишкової інфекції у дитячому садку

У Миколаєві поліцейські встановлюють обставини спалаху інфекційної хвороби у дошкільному навчальному закладі.
Вчора, 20 квітня, до відділення поліції № 2 Миколаївського районного управління поліції надійшло повідомлення від Миколаївського обласного центру контролю профілактики хвороб МОЗ України про виявлення випадків гострої кишкової інфекції серед дітей, які відвідують один із закладів дошкільної освіти міста.
Попередньо встановлено, що станом на сьогодні до медичного закладу із симптомами гострої кишкової інфекції звернулися батьки трьох дітей. Наразі двоє малолітніх пацієнтів перебувають на стаціонарному лікуванні, ще одна дитина проходить амбулаторне лікування. Усім дітям надається необхідна медична допомога, лікарі контролюють стан їхнього здоров’я.
За вказаним фактом слідчі поліції відкрили кримінальне провадження, попередньо, за ч. 1 ст. 325 Кримінального кодексу України – порушення санітарних правил і норм щодо запобігання інфекційним хворобам та масовим отруєнням.
Фахівці Миколаївського обласного центру контролю та профілактики хвороб МОЗ України проводять комплекс санітарно-епідеміологічних заходів, а також лабораторні дослідження для встановлення джерела інфекції та причин її виникнення. Перевіряється якість харчування, умови зберігання продуктів, санітарний стан приміщень та дотримання працівниками закладу відповідних норм.
Наразі співробітники поліції встановлюють усі обставини події.